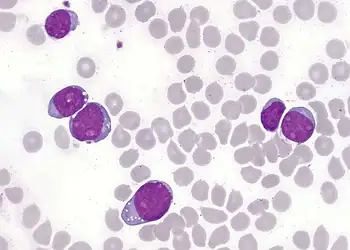
Células linfoblásticas T da leucemia aguda na medula óssea: poucas opções quando o tratamento principal falha - (crédito: WikimediaCommons/Divulgação )

As vendas no comércio cresceram 0,5% em outubro, na comparação com setembro. O resultado é a maior alta entre meses seguidos desde março de 2025, quando tinha crescido 0,7%.

Na comparação com outubro de 2024, o comércio brasileiro avançou 1,1%. No acumulado de 12 meses, o setor cresceu 1,7%, menor patamar desde dezembro de 2024, quando chegou a 4,1% de expansão.
Os dados fazem parte Pesquisa Mensal de Comércio, divulgada nesta quinta-feira (11) pelo Instituto Brasileiro de Geografia e Estatística (IBGE).
Veja o comportamento das vendas no comércio nos últimos meses:
- Março: 0,7%
- Abril: -0,3%
- Maio: -0,4%
- Junho: -0,1%
- Julho: -0,2%
- Agosto: 0,1%
- Setembro: -0,2%
- Outubro: 0,5%
Com os dados de outubro, o comércio está 0,5% abaixo do maior nível já registrado, em março de 2025. A série histórica do IBGE começa em 2000. O setor figura 9,6% acima do patamar pré-pandemia de covid-19 (fevereiro de 2020).
Sete das oito atividades com alta
Na passagem de setembro para outubro, sete das oito atividades pesquisadas apresentaram avanço:
- equipamentos e material para escritório, informática e comunicação: 3,2%
- combustíveis e lubrificantes: 1,4%
- móveis e eletrodomésticos: 1,0%
- livros, jornais, revistas e papelaria: 0,6%
- outros artigos de uso pessoal e doméstico: 0,4%
- artigos farmacêuticos, médicos, ortopédicos e de perfumaria: 0,3%
- hiper, supermercados, produtos alimentícios, bebidas e fumo: 0,1%
- tecidos, vestuário e calçados: -0,3%
De acordo com o gerente da pesquisa, Cristiano Santos, a venda de computadores, celulares e eletrodomésticos foram importante motor das vendas no mês.
“As empresas aproveitaram a depreciação [desvalorização] do dólar e performaram melhor, também por conta de promoções”, cita. A queda do dólar ante o real faz com que produtos importados fiquem mais em conta no país.
Junção de fatores
O analista acrescenta que houve “coincidências de fatores” para estimular o consumo. “Dentre eles, a inflação cedeu”, cita Santos, ao lembrar que houve deflação, com queda de preço na alimentação no domicílio, móveis e eletrodomésticos.
Outros fatores foram o mercado de trabalho aquecido e o crédito à pessoa física, que cresceu 2,1% em outubro.
Santos destaca que o crédito à pessoa física não tem sentido tanto o impacto da taxa básica de juros, a Selic, em 15% ao ano, que tende a refletir no encarecimento em toda a cadeia de crédito.
A Selic está mantida neste nível como uma estratégia do Banco Central para conter a inflação, que chegou a ficar 13 meses acima da meta do governo.
No comércio varejista ampliado, que inclui atividades de atacado ─ veículos, motos, partes e peças; material de construção; e produtos alimentícios, bebidas e fumo ─ o indicador avançou 1,1% de setembro para outubro e apresenta estabilidade (0%) no acumulado de 12 meses.
De acordo com o gerente da pesquisa, Cristiano Santos, o desempenho do varejo ampliado em outubro “foi bastante influenciado por veículos, motos, partes e peças, e pela atividade de atacado especializado em produtos alimentícios, bebidas e fumo”.
Por Agência Brasil